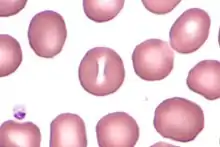

Stomatocyte
Un stomatocyte est une forme anormale de globule rouge (plus correctement dénommé hématie ou érythrocyte) dans le sang humain. Cette dénomination est liée à l'aspect du stomatocyte.
Pour rappel, un érythrocyte normal se présente de profil comme un disque biconcave de couleur homogène, et de face comme un disque dont le centre est plus clair : c'est une sorte de poche contenant l'hémoglobine. Le centre clair est grossièrement circulaire. Du fait de la biconcavité, la région centrale est moins épaisse (0,8 micromètre) que la région périphérique (2,6 micromètres)[1]. Dès lors la périphérie est la plus apte à une fixation maximale de l'hémoglobine et apparaît plus colorée au microscope car c'est l'hémoglobine qui fixe le fer et donne son aspect rose ou rouge à l'hématie.
Les stomatocytes, au contraire n'ont qu'une concavité et de profil prennent l'aspect d'une cupule[2],[3]. Dès lors, la zone centrale apparaît comme une fente rectiligne de couleur claire qui l'a fait initialement comparer à une bouche humaine (en grec ancien la bouche se dit stoma)[2],[3]. L'image de comparaison la plus frappante est peut être celle du panneau de circulation B1 de sens interdit[4].
Leur taille et leur forme de face est celle des hématies normales[5]. Leur présence n'est pas forcément pathologique, en effet il peut s'agir d'un artéfact lors de la préparation du frottis sanguin ou chez des patients recevant de la phénothiazine (ou de la chlorpromazine) ou de l'hydroxyurée car les stomatocytes peuvent se former à pH acide.
Les stomatocytes sont présents en nombre élevé chez les patients porteurs de maladies du foie, en particulier alcooliques chroniques, de certains cancers et maladies cardiaques[5]. Les stomatocytes sont caractéristiques de quelques maladies rares comme la stomatocytose héréditaire avec hématies hyperhydratées (dans lesquelles ont observe une augmentation de volume par hydrocytose et de nombreux stomatocytes sur frottis sanguin) ; ou comme la stomatocytose héréditaire avec hématies déshydratées (avec aspect de xérocytose et sur le frottis mélange de stomatocytes et d'hématies en cible ; ou dans diverses anomalies lipidiques comme la maladie de Tangier ou la sitostérolémie héréditaire etc.[5]. Leur présence est peu spécifique dans les anémies hémolytiques acquises[5].
Références
    
- (en) E. Evans et Y.-C. Fung, « Improved Measurements of the Erythrocyte Geometry », Microvascular Research, vol. 4, , p. 335-347 (DOI 10.1016/0026-2862(72)90069-6).
 - « Stomatocyte », sur Dictionnaire médical de l'Académie de Médecine, (consulté le ).
 - « Stomatocyte », sur Académie nationale de Pharmacie (consulté le ).
 - « Arrêté du 7 juin 1977 modifié relatif à la signalisation des routes et autoroutes (Journal officiel du 13 août 1977) », sur Ministère de l'équipement (consulté le ).
 - « Morphologie érythrocytaire (partie 2) : anomalies de forme des GR », sur Hematocell, (consulté le ).
 
- Portail de la médecine
 - Portail de l’hématologie